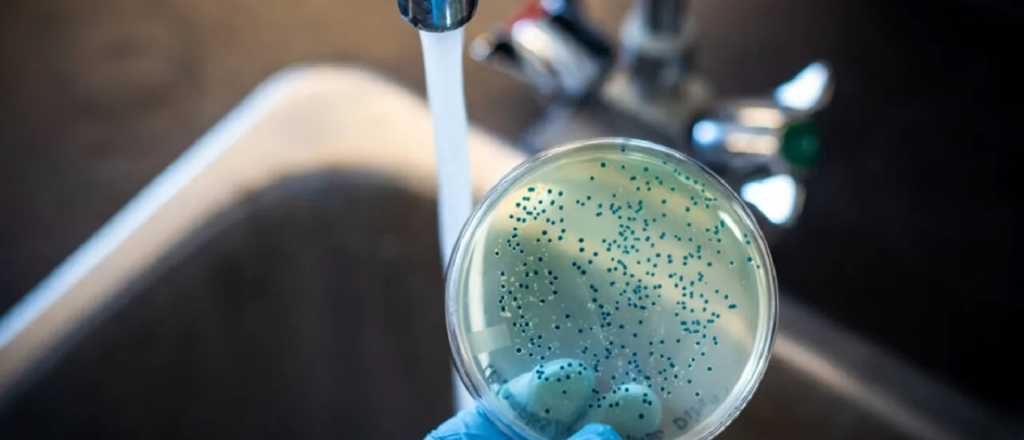
Brote de fiebre tifoidea: qué pasa en Mendoza

Desde la Dirección de Epidemiología afirmaron que hay casos esporádicos. Y remarcan la importancia de tener el calendario de vacunación al día.
Brote de fiebre tifoidea: qué pasa en Mendoza
A través del Boletín Epidemiológico del Ministerio de Salud de la Nación se notificó sobre un brote de fiebre tifoidea en Ciudadela, Buenos Aires, en el que se confirmaron 10 casos. En Mendoza desde la Dirección de Epidemiología afirmaron que hay casos esporádicos y desde el área remarcaron la importancia de la vacunación.
Andrea Falaschi, directora de Epidemiología de Mendoza, durante una actividad de la semana de vacunación que se llevó a cabo en el barrio de La Gloria en Godoy Cruz, sostuvo que a través de la vacunación se puede sostener la eliminación de más de 30 enfermedades inmunoprevenibles, como es el caso de la fiebre tifoidea.
En Mendoza, fuentes del Ministerio de Salud afirmaron al Post que "tenemos casos de manera ocasional, muy ocasional, y que no están relacionados o no son del tipo de casos que están en estudio en el Malbrán que pertenecen a Ciudadela".
En cuanto a la prevención Falaschi afirmó "se trata de llevar a las poblaciones más desatendidas o que quedan a veces más relegadas y con menor acceso a las vacunas la oportunidad de vacunarse. Si bien la provincia de Mendoza tiene acceso a la vacunación a través de todos sus efectores sanitarios, esta semana nos adherimos a la Semana de Vacunación de las Américas con el fin de sostener los logros que se han alcanzado en la región de las Américas y trabajar sobre la eliminación de más de 30 enfermedades infecciosas, que son enfermedades inmunoprevenibles".
Asimismo, la directora remarcó la importancia de que las personas se vacunen y respetar el esquema de vacunación de los recién nacidos y las infancias. "La vacunación es un acto individual y también social. Cuando uno tiene su calendario al día, no solo se protege a uno mismo, sino que también protege a la comunidad. Lo que tienen las vacunas es lo que llamamos inmunidad de rebaño. Cuando toda la población está inmunizada se evita que ingresen enfermedades infecciosas", defendió Falaschi .
En conmemoración de la Semana de Vacunación de las Américas, el Ministerio de Salud y Deportes junto con la Municipalidad de Godoy Cruz realizaron una actividad intensiva de vacunación a miembros de la comunidad, en el Polideportivo Padre Contreras del Barrio La Gloria, Godoy Cruz.
El caso de fiebre tifoidea en Buenos Aires
En el Boletín Epidemiológico del Ministerio de Salud de la Nación se informó sobre un brote de fiebre tifoidea en Ciudadela, Buenos Aires en el que se confirmaron 10 casos y una muerte que están siendo investigadas. Según las investigación epidemiológica las personas afectadas viven en dos edificios vecinos que están conectados por el mismo tanque de agua, el cual es provisto de agua de pozo y no de red. "Podría haber sido al tomar directamente el agua o al usarla para lavarse los dientes o los alimentos" dijo subsecretaria de Planificación Estratégica del Ministerio de Salud de la provincia de Buenos Aires, Leticia Ceriani.
En el edificio porteño a comienzos de año se produjo un corte en la provisión de agua que duró dos semanas. Una de las hipótesis que se maneja es que el agua se habría contaminado por la bacteria que causa la fiebre tifoidea.
¿Qué es la fiebre tifoidea?
Según la Administración Nacional de Medicamentos, Alimentos y Tecnología Médico (ANMAT) la fiebre tiroidea es una enfermedad infecciosa causada por una bacteria - Salmonella Typhi- que puede transmitirse por agua o alimentos contaminados. Compromete el intestino y puede extenderse a otros órganos.
Luego del ingreso de la bacteria en el organismo comienzan los síntomas, que pueden ser fiebre alta prolongada, cansancio, cefaleas, náuseas, dolor abdominal, estreñimiento o diarrea.
En el caso de no recibir tratamiento a tiempo y adecuado, puede derivar en complicaciones graves como perforaciones intestinales o infecciones generalizadas.
¿Cómo prevenir la fiebre tiroidea?
Desde la ANMAT recomiendan el uso de agua segura para:
-el lavado frecuente de manos con agua y jabón. Luego de haber ido al baño, cambiar pañales, o estar en contacto con animales o sus heces y antes de preparar o consumir alimentos.
-para preparar jugos o infusiones.
-para el lavado de frutas y verduras, especialmente las que se consumen crudas.
-para el lavado de dientes.
-en la desinfección de utensilios y superficies.
En el caso de que el agua venga de un pozo, se recomienda hervir durante 2 a 3 minutos, también se puede agregar un poco de lavandina sólo la que es "apta para desinfectar agua" y registrada en ANMAT por cada litro dejar reposar 30 minutos .
Ver: Acueducto vandalizado en La Favorita: qué dijeron desde Irrigación